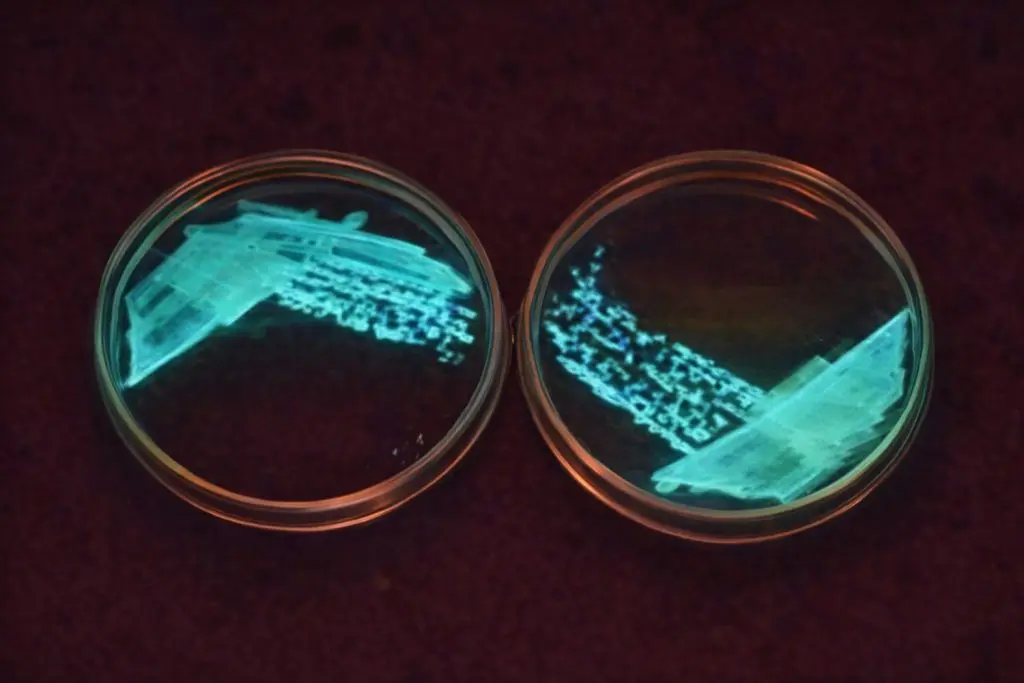

Bioluminescent bacteria: પાદરા સ્થિત એમ. કે. અમીન કોલેજમાં માઇક્રોબાયોલોજી વિષયમાં અભ્યાસ કરતા બે યુવા વિદ્યાર્થીઓએ વૈજ્ઞાનિક ક્ષેત્રે નોંધપાત્ર સિદ્ધિ હાંસલ કરી છે. અર્ણવ ઢમઢેરે અને હરિઓમ પાઠકે દરિયાના પાણીમાંથી પ્રકાશ ઉત્પન્ન કરનારા બાયોલ્યુમિનેસેન્સ બેક્ટેરિયાની સફળ શોધ કરી છે.
કોલેજના વિદ્યાર્થીઓએ કરી અદભુત શોધ
મહારાજા સયાજીરાવ યુનિવર્સિટી (MSU) સંલગ્ન એમ. કે. અમીન કોલેજના બે યુવા વિદ્યાર્થીઓએ એક અદભુત શોધ કરી છે. B.Sc. માઇક્રોબાયોલોજી વિષય સાથે અભ્યાસ કરતા અર્ણવ ઢમઢેરે અને હરિઓમ પાઠકે દરિયાના પાણીમાંથી પ્રકાશ ઉત્પન્ન કરનારા બાયોલ્યુમિનેસેન્સ બેક્ટેરિયાની સફળ શોધ કરી છે. આ શોધ શૈક્ષણિક જગત સાથે પર્યાવરણ અને બાયોટેકનોલોજીના ક્ષેત્રે પણ મહત્વપૂર્ણ માનવામાં આવી રહી છે.
અંધકારમાં કુદરતી રીતે પ્રકાશ ઉત્પન્ન કરતા બેક્ટેરિયા
આ સંશોધન કાર્ય પ્રોફેસર દેવર્ષિ ગજ્જર અને ડૉ. પ્રિયા જિશ્નના વૈજ્ઞાનિક માર્ગદર્શન હેઠળ કરવામાં આવ્યું હતું. વિદ્યાર્થીઓએ મહારાષ્ટ્રના રત્નાગીરી વિસ્તારના દરિયાના પાણીમાંથી નમૂનાઓ એકત્રિત કરી, તેમાં હાજર વિશિષ્ટ બેક્ટેરિયાની ઓળખ, અલગીકરણ અને અભ્યાસ કર્યો હતો. બાયોલ્યુમિનેસેન્સ બેક્ટેરિયા અંધકારમાં કુદરતી રીતે પ્રકાશ ઉત્પન્ન કરે છે, જેના કારણે તે વૈજ્ઞાનિક સંશોધનમાં ખાસ રસનો વિષય બને છે.
સંશોધન કરવું અત્યંત પડકારજનક
અર્ણવ અને હરિઓમે જણાવ્યું કે, આ બેક્ટેરિયાનું અલગીકરણ અને સંશોધન કરવું ટેકનિકલી અત્યંત પડકારજનક પ્રક્રિયા હતી. લેબોરેટરીમાં સ્વચ્છતા, ચોકસાઈ અને વૈજ્ઞાનિક અભિગમ જરૂરી હતો. લગભગ અગિયાર મહિના સુધી સતત મહેનત, ધીરજ અને શિસ્તબદ્ધ પ્રયોગો બાદ આ સિદ્ધિ પ્રાપ્ત થઈ છે.
આ પણ વાંચો: પાદરા SBIના પૂર્વ મેનેજર સામે સાતમી ફરિયાદ નોંધાઈ, ઑડિટમાં રૂ. 10 લાખની લોન કૌભાંડનો પર્દાફાશ
યુવા વિદ્યાર્થીઓ માટે પ્રેરણારૂપ ઉદાહરણ
આ દરમિયાન અનેક વખત નિષ્ફળતા આવી, પરંતુ માર્ગદર્શકોના સહયોગ અને આત્મવિશ્વાસના કારણે સફળ થઈ શક્યા. MK અમીન કોલેજ અને MS યુનિવર્સિટી માટે આ સિદ્ધિ ગૌરવપૂર્ણ બની છે, જ્યારે શહેરના યુવા વિદ્યાર્થીઓ માટે આ સંશોધન પ્રેરણારૂપ ઉદાહરણ બની રહ્યું છે.
બાયોલ્યુમિનેસેન્ટ બેક્ટેરિયાનો ઉપયોગ શું?
આ સંશોધન ભવિષ્યમાં પર્યાવરણ વિજ્ઞાન, બાયોટેકનોલોજી અને એપ્લાઇડ માઇક્રોબાયોલોજીના ક્ષેત્રે ઉપયોગી સાબિત થવાની શક્યતા છે. બાયોલ્યુમિનેસેન્ટ બેક્ટેરિયાનો ઉપયોગ પ્રદૂષણ નિરીક્ષણ, મેડિકલ રિસર્ચ અને બાયો-ઇન્ડિકેટર તરીકે થઈ શકે છે. હાલમાં આ બેક્ટેરિયાનું પેથોલોજીકલ પૃથક્કરણ બાકી છે, જે પૂર્ણ થયા બાદ તેના વધુ વ્યાપક ઉપયોગ અંગે માર્ગ ખુલશે.
